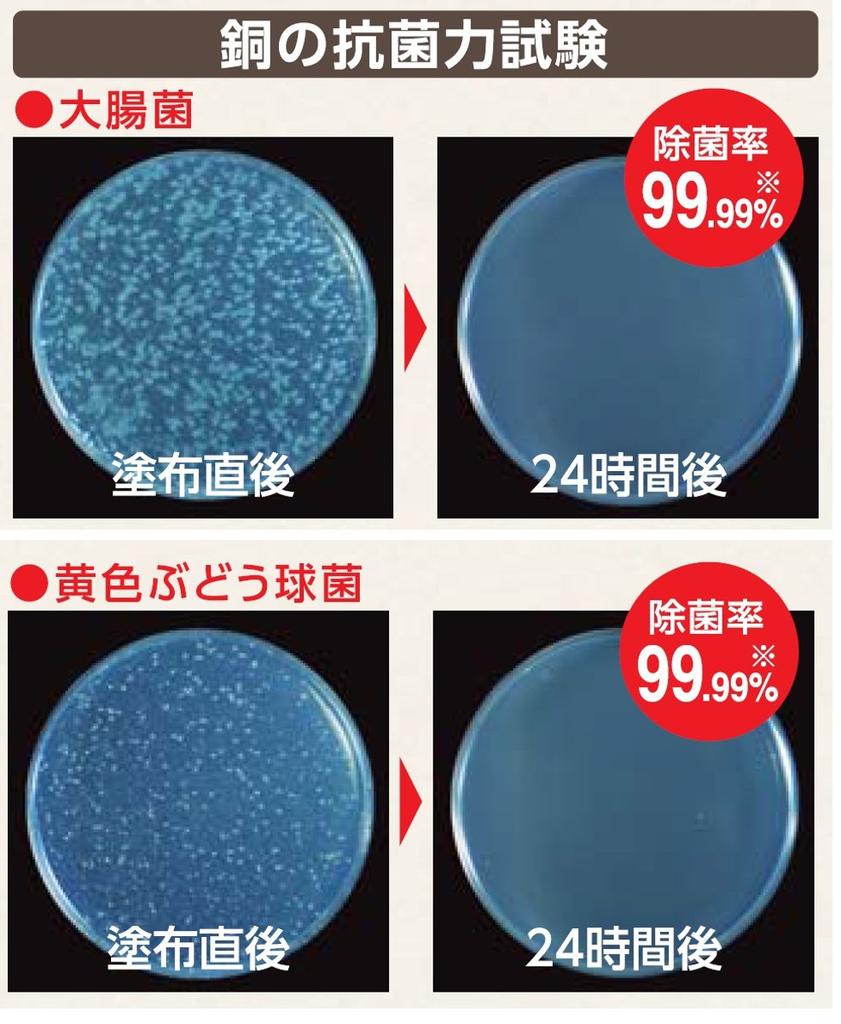
SANEI Sink Drain Stopper Slime Basket, Prevention, 144mm, Copper, PH691F-3

The website doesn't support your browser. Please update your browser or download a different one
SANEI Sink Drain Stopper Slime Basket, Prevention, 144mm, Copper, PH691F-3
Current price
Price €67.40VAT included

Delivery 11‑31 business days

Delivery €3.94
Returns & refunds
Secure payments






Our support team speaks English
Safety & compliance
Description
Premium SPEED
4.8/200
Similar products